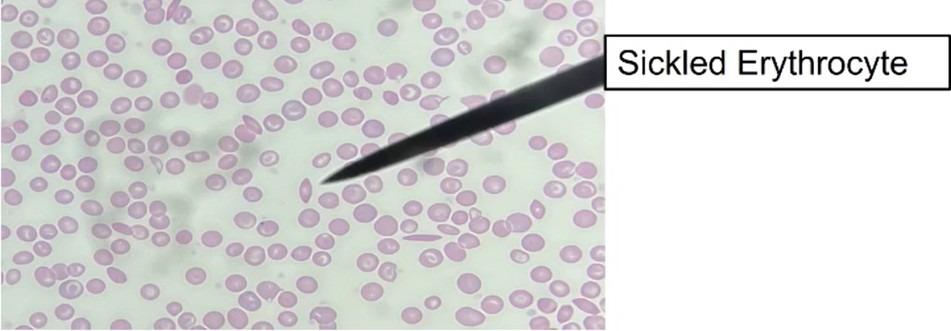
<p>What is the pointer showing&nbsp;</p>

1/32
Looks like no tags are added yet.
Name  | Mastery  | Learn  | Test  | Matching  | Spaced  | 
|---|
No study sessions yet.

What connective tissue is shown
FIbrocartilage
Location: Intervertebral discs of the spine or pubic symphysis
Cell: Chondrocyte
What is the pointer showing
Sickle cell anemia. (Flat compared to the usual round blood cells)

What type of connective tissue is this
Dense White Fibrous Regular Connective Tissue.
Location : Ligaments and tendons
Cell: Fibroblast

What connective tissue is shown
Compact bone / Osseous Tissue
Location : Bones
Cells : Osteocyte

What tissue is shown
Reticular connective tissue
Location : Lymph node & Spleen
Cell : Fibroblast

What tissue is shown
Dense White Fibrous Irregular Connective Tissue
Location : Dermis of skin & organ capsules
Cell : Fibroblast

What tissue is shown
Elastic Cartilage
Location : Ear & epiglottis
Cell : Chondrocyte

What tissue is shown
Hyaline Cartilage
Location : Epiphysis & trachea
Cell : Chrondrocyte

What tissue is shown
Adipose Connective Tissue
Location : Hypodermis
Cell : Adipocyte

What cells are shown
Simple columnar epithelium
Location : hollow walls of organs & gallbladder

What cells are shown
Simple Squamous Epithelial
Location : Bowman’s Capsule (as shown in image, but can also be found in the endothelium & alveoli)


What cell is shown
Non-Keratinized stratified squamous epithelium
Location : Oral mucosa, vagina, esophagus


Label all parts
1- Goblet Cells
2- Cillia
3- Pseudostratified ciliated columnar epithelium
Location : Trachea


Label all parts
1- simple cuboidal epithelium
2- lumen
Location : Renal/kidney tubules, thyroid/pituitary gland


Label all parts
1- simple squamous epithelium
2- glomerulus (bowman’s capsule)
3- simple cuboidal epithelium


What cells are shown
Keratinized stratified squamous epithelium
Loction : epidermis of skin


What cells are shown
Transitional epithelium
Location : Bladder
Location for simple squamous epithelium
Alveoli (lungs), Glomerular (capsule of kidney), & endothelium (blood vessels)
Location for simple cuboidal epithelium
Kidney tubules, thyroid/pituitary gland
Location for transitional epithelium
Bladder
Location for simple columnar epithelium
Stomach down -
small intestine, colon, stomach, gallbladder, uterus
Location for pseudostratified ciliated columnar epithelium
Trachea, bronchi, auditory canal of middle ear
Location for non-keratinized stratified squamous epithelium
espohagus, pharynyx, vagina, tongue, anus
Location for keratinized stratified squamous epithelium
Skin & scalp

What epithelial tissue is this
Stratified cuboidal epithelium, found in sweat glands
Where is stratified cuboidal epithelium found
sweat glands, not thyroid/pituitary glands like simple cuboidal

What tissue is shown
Fibrocartilage

What tissue is shown
Dense irregular connective tissue (epidermis)

What tissue is shown
Dense regular connective tissue

What tissue is shown
Reticular connective tissue (lymph nodes, spleen)

What epithelial is highlighted
Simple cuboidal epithelium

What cell is shown
Simple columnar epithelium

What cell is highlighted below
simple squamous epithelium